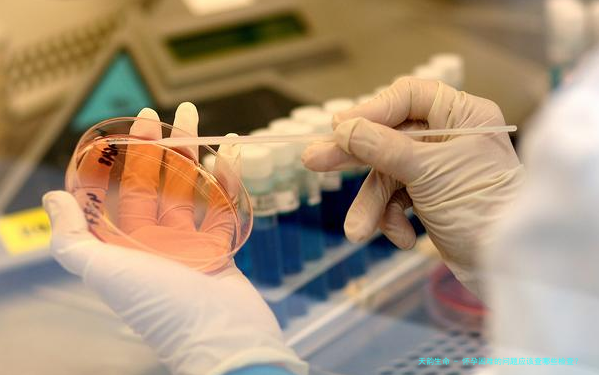

一、常规检查
在怀孕前进行常规检查可以了解女性的身体状况,确保顺利怀孕。这些常规检查包括身体检查、血常规、尿常规、肝功能、肾功能、免疫功能、凝血功能以及血型等。身体检查可以检查女性的身体状况是否适合怀孕,如有慢性疾病需要治愈或控制,以提高怀孕的和胎儿的健康。此外,还要进行血常规和尿常规检查,以了解女性的血红蛋白、红细胞计数、尿蛋白等指标是否正常,排除贫血、尿道感染等情况。肝功能、肾功能、免疫功能和凝血功能等也需要检查,以确保女性的身体各项机能都正常。后,还要进行血型检查,尤其是Rh血型,以预防血型不符引起的孕妇免疫性病变。二、妇科检查
妇科检查是怀孕前必不可少的检查之一。妇科检查主要包括子宫、输卵管和卵巢的检查。通过宫颈抹片可以了解妇女的宫颈状况,检查是否存在炎症、异形细胞等情况。此外,还需要进行宫腔镜检查,以了解子宫的内膜厚度、异物是否存在等情况。输卵管和卵巢的检查可以通过超声波、腹腔镜等技术进行,以排除输卵管堵塞、卵巢囊肿等情况。三、遗传检查
遗传检查是非常重要的一项检查,可以帮助了解夫妻双方是否携带某些遗传病的基因。在怀孕前进行遗传检查可以可能存在的风险,如果夫妻双方都是携带者,那么可能孩子患有遗传病的风险就会增加。常见的遗传病包括地中海贫血、先天性心脏病、遗传性聋哑症等。进行遗传检查可以预防这些遗传病的发生,也可以选择性地进行试管婴儿或遗传学诊断。四、其他必要检查
除了上述的常规检查、妇科检查和遗传检查,还有一些其他必要的检查需要进行。例如,甲状腺功能检查可以了解甲状腺功能是否正常,甲状腺功能异常可能会影响怀孕和胚胎发育。此外,还需要进行糖耐量试验,以了解是否患有妊娠期糖尿病。如果有家族史或高龄孕妇,还需要进行唐氏筛查和羊水穿刺等检查,以排除胎儿异常。 综上所述,怀孕前需要进行一系列的检查,以确保女性身体状况良好,胎儿在母体内能够得到良好的环境。常规检查、妇科检查、遗传检查和其他必要的检查都是非常重要的,可以帮助预防并及早发现可能的问题,为顺利怀孕提供保障。因此,在计划怀孕时,一定要及时进行这些检查,提前了解可能存在的困难和风险,以便采取适当的措施。
转载请注明出处。